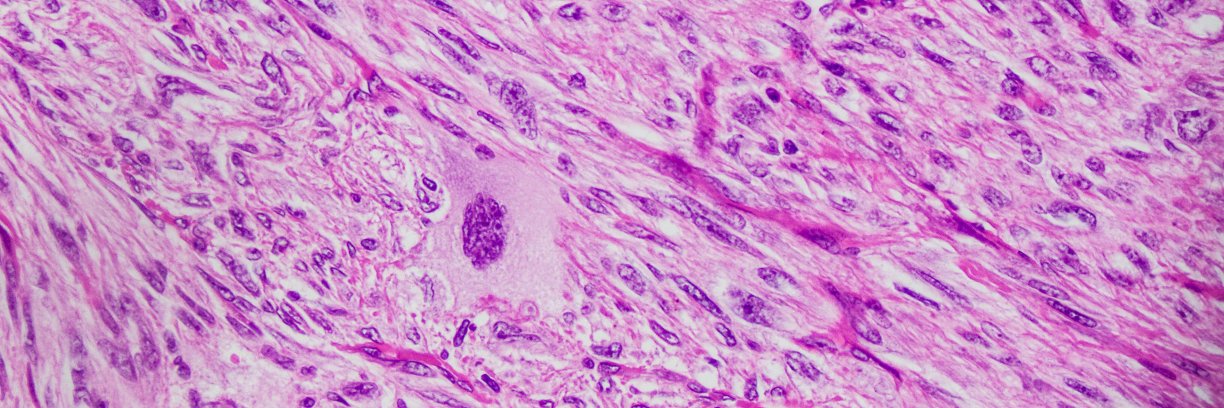
Michael P. Lee MD banner

Michael P. Lee MD
1K posts

Michael P. Lee MD
@MPLEEMD
Father of 2, husband, lover of pink and purple art. Dermatopathologist @AW Dermatopathology. @Tulane Dermatopathology.





























@lcharlesdvm @kriyer68 @drjudymelinek @kabeerkshah @ALBoothMD @Path_Matt @smlungpathguy @kis_lorand @lara_pijuan @DrAldehyde @BinXu16 @DrGeeONE Trichofolliculoma: big central cyst opening to epidermis w multiple baby hair follicles growing out of cyst wall. Here are pics from my upcoming #dermpath #PathSurvivalGuide book from @innovpathpress. bit.ly/2Te2haB

#Pathologists: I’m giving a talk on social media in Puerto Rico this a.m. Trying to convince audience to join Twitter. What’s your favorite part about #Pathology Twitter? What are Twitter non-users missing out on? I’ll screenshot some responses & use in my talk. thx! 🙏🏻






